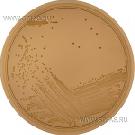
Nutrient Agar (ISO)
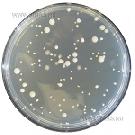
Orange Serum Agar
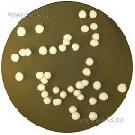
Oxytetracycline Glucose Yeast Extract Agar (O.G.Y.E.)
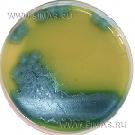
PEMBA (Bacillus cereus Medium)
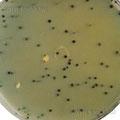
Perfringens Agar (O.P.S.P.)
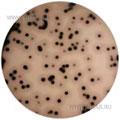
Perfringens Agar (T.S.C.)
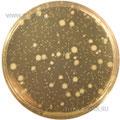
Plate Count Agar
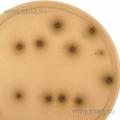
Potato Dextrose Agar
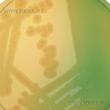
Pseudomonas Isolation Medium
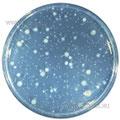
R2A Medium
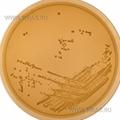
Raka-Ray № 3 Agar
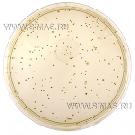
Reinforced Clostridial Agar
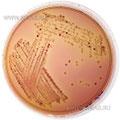
Rhamnose MacConkey (VTEC O26) Agar

Подписаться на рассылку
Компания СИМАС
Москва, Варшавское шоссе д.125 стр.1
+7 (495) 980 - 29 - 37, +7 (916) 942 - 65 - 95
info@simas.ru
|
Полный перечень сред Lab M
1 | 2 | 3 | 4 | 5 | 6 | 7
Nutrient Agar
 Производитель: Lab M
Описание: Агар питательный агар для культивирования микроорганизмов.
Этап: Исследование |
|
|
|
Nutrient Agar (ISO)
Производитель: Lab M
Описание: Агар питательный агар для культивирования бактерий по стандарту ISO 6579:2002, ISO 10273:2003 и ISO 16654:2001.
Этап: Исследование |
|
|
|
Nutrient Broth «Е»
 Производитель: Lab M
Описание: Бульон общего назначения для культивирования бактерий.
Этап: Исследование |
|
|
|
Nutrient Broth № 2 ВР
 Производитель: Lab M
Описание: Бульон общего назначения для культивирования бактерий (по Фармакопее Великобритании).
Этап: Исследование |
|
|
|
NZCYM Broth
 Производитель: Lab M
Описание: Бульон улучшенный для повышенного выхода фага Lambda.
Этап: Исследование |
|
|
|
NZY Broth
 Производитель: Lab M
Описание: Бульон для повышенной репликации фага Lambda.
Этап: Исследование |
|
|
|
O157 Broth (MTSB)
 Производитель: Lab M
Описание: Бульон MTSB для селективного обогащения энтеропатогенных E.coli.
Этап: Исследование |
|
|
|
Orange Serum Agar
Производитель: Lab M
Описание: Агар апельсиново-сывороточный для выделения бактерий, вызывающих порчу цитрусовых.
Этап: Исследование |
|
|
|
O.R.S.I.M. (Oxacillin Resistant Staphylococci Isolation Medium)
 Производитель: Lab M
Описание: Агар ORSIM для селективного выделения оксациллиноустойчивых стафилоккков.
Этап: Исследование |
|
|
|
Oxytetracycline Glucose Yeast Extract Agar (O.G.Y.E.)
Производитель: Lab M
Описание: Агар OGIE с окситетрациклином для селективного подсчета дрожжей и плесеней.
Этап: Исследование |
|
|
|
PALCAM Agar Base
 Производитель: Lab M
Описание: Агар селективный PALCAM для идентификации Listeria monocytogenes.
Этап: Исследование |
|
|
|
PALCAM Broth
 Производитель: Lab M
Описание: Бульон PALCAM для селективного обогащения продуктов и образцов окружающей среды при исследовании на листерии.
Этап: Исследование |
|
|
|
PEMBA (Bacillus cereus Medium)
Производитель: Lab M
Описание: Агар PEMBA для выделения и подсчета Bacillus cereus.
Этап: Исследование |
|
|
|
Peptone Water
 Производитель: Lab M
Описание: Среда - пептонная вода для изучения ферментации углеводов бактериями.
Этап: Исследование |
|
|
|
Perfringens Agar (O.P.S.P.)
Производитель: Lab M
Описание: Агар O.P.S.P. для подсчета Cl.Perfringens в продуктах.
Этап: Исследование |
|
|
|
Perfringens Agar (T.S.C.)
Производитель: Lab M
Описание: Агар TSC для подсчета и предварительной идентификации Cl.Perfringens.
Этап: Исследование |
|
|
|
Plate Count Agar APHA
 Производитель: Lab M
Описание: Агар для определения ОМЧ поверхностным и глубинным методами по рекомендации АРНА.
Этап: Исследование |
|
|
|
Plate Count Agar
Производитель: Lab M
Описание: Агар для определения ОМЧ поверхностным и глубинным методами.
Этап: Исследование |
|
|
|
PREP (Bacillus cereus Medium)
 Производитель: Lab M
Описание: Агар для подсчета и дифференциации Bacillus cereus.
Этап: Исследование |
|
|
|
Potato Dextrose Agar
Производитель: Lab M
Описание: Агар картофельно-декстрозный. Рекомендован АРНА для подсчета дрожжей и плесеней в кормах.
Этап: Исследование |
|
|
|
Pseudomonas aeruginosa Isolation Medium
 Производитель: Lab M
Описание: Агар (основа) для селективного выделения Pseudomonas aeruginosa.
Этап: Исследование |
|
|
|
Pseudomonas Isolation Medium
Производитель: Lab M
Описание: Агар (основа) для селективного выделения Pseudomonas spp.
Этап: Исследование |
|
|
|
R2A Medium
Производитель: Lab M
Описание: R2A Medium - агар R2 для подсчета гетеротрофных бактерий в воде.
Этап: Исследование |
|
|
|
R2A Broth
 Производитель: Lab M
Описание: Бульон R2 cо сниженной питательностью для мембранных методов подсчета бактерий в образцах воды.
Этап: Исследование |
|
|
|
Raka-Ray № 3 Agar
Производитель: Lab M
Описание: Агар Рака-Рэя № 3 для подсчета микроорганизмов при производстве пива.
Этап: Исследование |
|
|
|
Raka-Ray 3 Agar (Increased Gel Strength)
 Производитель: Lab M
Описание: Агар Рака-Рэя №3 повышенной плотности для подсчета микроорганизмов при производстве пива.
Этап: Исследование |
|
|
|
Rappaport Vassiliadis Medium (RVS)
 Производитель: Lab M
Описание: Бульон Раппапорта-Вассилиадиса (RVS) для селективного обогащения при выделении сальмонелл.
Этап: Исследование |
|
|
|
Reinforced Clostridial Agar
Производитель: Lab M
Описание: Агар улучшенный для подсчета клостридий при поверхностном посеве.
Этап: Исследование |
|
|
|
Reinforced Clostridial Broth
 Производитель: Lab M
Описание: Бульон улучшенный для выделения клостридий с небольшим обсеменением образцов.
Этап: Исследование |
|
|
|
Rhamnose MacConkey (VTEC O26) Agar
Производитель: Lab M
Описание: Агар МакКонки с рамнозой для энтеропатогенных серотипов кишечной палочки О-126.
Этап: Исследование |
|
|
|
1 | 2 | 3 | 4 | 5 | 6 | 7
|